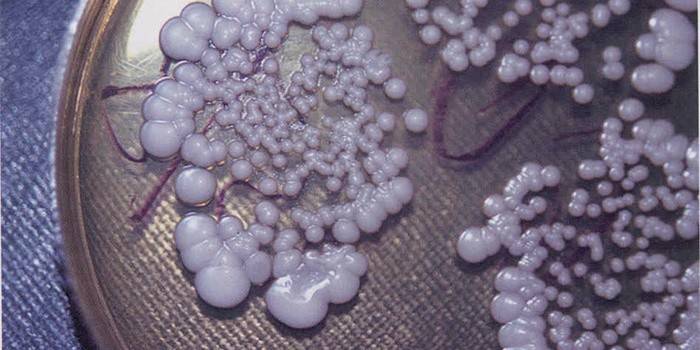

Colpitis: príznaky a liečba u žien
Odborníci tvrdia, že kolpitída je diagnostikovaná u veľkej väčšiny pacientov s prenatálnymi klinikami. Ochorenie sa vyskytuje medzi čestným sexom v období pôrodu, sú mu však vystavené dievčatá aj ženy, pre ktoré už začala jesenné obdobie života. To spôsobuje gynekológom ťažkú kolpitídu a príznaky a liečba žien rôzneho veku sa veľmi líšia. Čím je choroba pozoruhodná, aké príznaky rozpoznáva a ako sa jej zbaviť?
Čo je kolpitída u žien
Pacienti, ktorí prvýkrát počuli ich diagnózu, zaujímajú: kolpitída v gynekológii - čo je to? Čo je choroba nebezpečná, aká bude liečba? Kolpitída alebo iná vaginitída, kód N 76.0 - N 76.1 podľa ICD - 10, je zápal sliznicového povrchu pošvy, vonkajších genitálií, krčka maternice, ktorý je spôsobený patogénnymi baktériami, ktoré na ne dopadli zvonku alebo zvýšením počtu nebezpečných mikroorganizmov v ženskej mikroflóre.

Dôvody, prečo môže kolpitída vagíny rušiť, sú mnohé:
- nedodržiavanie pravidiel osobnej hygieny (častejšie pre deti);
- slabá imunita;
- promiskuitný sexuálny styk;
- neoprávnené ošetrenie antibiotikami;
- zmena podnebia;
- na sebe nepohodlné oblečenie, spodná bielizeň zo syntetických tkanín;
- mechanické, tepelné poškodenie vagíny;
- hormonálne poruchy;
- oslabenie funkcie vaječníkov počas menopauzy.
Príznaky kolpitídy
Gynekológovia rozlišujú niekoľko typov príznakov kolpitídy a liečba u žien sa bude u každého z nich líšiť. Trichomóny, ktoré často vedú k nečitateľnosti pri pohlavnom styku alebo pri stálom kontakte s jedným, ale nie sú vidieť u verného partnera, sa prejavia oveľa ostrejšie ako atrofické (senilné), spôsobené prirodzeným vyhynutím reprodukčných funkcií. Kandidóza kolpitída sa necíti okamžite, ale niekoľko dní alebo týždňov po poškodení slizníc.
starý

Mnoho žien nad päťdesiatou mylne verí, že spolu so schopnosťou opäť sa stať matkou, ich náchylnosť na gynekologické infekcie ustupuje. Reagujú s zmätkom na atrofickú kolpitídu: čo to je a ako liečiť chorobu? Medzitým nie je taký zápal v žiadnom prípade neobvyklý. Z tohto dôvodu sú príznaky atrofickej kolpitídy dôležité pre každú dospelú ženu. Tieto zahŕňajú:
- suchosť v pošve, zníženie množstva lubrikantu produkovaného telom;
- mierne krvácanie počas pohlavného styku;
- nepohodlie v perineu.
Trichomonas
Trichomonas colpitis u žien označuje sexuálne prenosné choroby. Baktéria Trichomonas môže vstúpiť do tela, keď používa osobné hygienické potreby iných ľudí a iné gynekologické choroby. Príznaky trichomonas alebo inak bakteriálnej kolpitídy sú:
- penový výboj s nečistotami hnisovej žltej alebo zelenkavej farby;
- svrbenie, pálenie vo vonkajšej oblasti genitálu;
- menštruačné nepravidelnosti;
- rezné bolesti v dolnej časti brucha;
- nepohodlie pri pohlavnom styku.
kandidóza
Kandidóza alebo kvasinková kolpitída sú u žien dobre známe ako drozd. Jeho odstránenie je veľmi ľahké, jeho odstránenie je oveľa ťažšie. Lekári sa často musia zbaviť mozgu nad takýmito príznakmi a liečbou kolpitídy u žien, ktoré ochorejú za rôznych okolností, ktoré sa od seba radikálne líšia. Ochorenie sa prejavuje nasledujúcimi príznakmi:
- bohaté biele mliečne biele sfarbenie, ktoré pripomína konzistenciu tvarohu;
- neznesiteľné svrbenie vo vagíne, v pyskoch;
- bolesť pri pohlavnom styku.
Liečba kolpitídy u žien
Špecialisti rozlišujú dve hlavné formy kolpitídy: chronickú a akútnu. Sluggish zápal vyžaduje dlhé ošetrenie - nielen miestne, ale aj všeobecné. V boji proti akútnej kolpitíde musíte najskôr odstrániť rušivé príznaky a až potom bojovať so zdrojom infekcie. Násilný zápal je liečiteľnejší ako dlhodobý zápal. Lekári odporúčajú počas tohto obdobia upustiť od pohlavného styku.
lieky

Colpitída akejkoľvek formy môže byť liečená nie jednou, ale niekoľkými liečivami naraz, spolu so špeciálnymi postupmi: miestne kúpele a douching. V recepte sú často uvedené sviečky „Terzhinan“, „Vokadin“, „Pimafucin“ alebo „Genferon“, ktoré majú antimikrobiálne a protiplesňové vlastnosti. Lekári odporúčajú striedať vaginálne kúpele s chlorofylitom zriedeným vo vode s výplachom emulzie streptomycínu obohatenej o šípkové a broskyňové oleje. Režim liečby kolpitídy je vybraný individuálne.
Ľudové lieky

Tradičná medicína odporúča liečiť kolpitídu doučovaním s odvarmi a infúziami bylín. Pre každý postup je lepšie pripraviť čerstvú tekutinu:
- 1 polievková lyžica. l. dubová kôra naleje 250 ml vriacej vody, trvá na tom 12 hodín;
- 1 polievková lyžica. l. nakrájanú husaciu cinquefoil mix s 2 lyžicami. l. harmanček, zalejeme 1000 ml vriacej vody, nechať to trvať, napätie;
- 1 polievková lyžica. l. lastovičník, trvať na 250 ml vriacej vody, kmeň.
Počas tehotenstva
Je chybou veriť, že kolpitída počas tehotenstva je úplne dobrovoľná. Naopak: často spôsobuje komplikácie počas pôrodu a zdroj infekcie pre dieťa. Hlavnou vecou nie je samoliečba a prísne dodržiavanie pokynov lekára. Nie všetky lieky proti kolpitíde sa môžu užívať počas tehotenstva, preto je potrebné, aby liečebný režim, lieky predpisoval gynekológ, najlepšie zo všetkých, ktorý vedie tehotenstvo od prvých dní.
Video: ako liečiť kolpitídu
Kolpitída je veľmi zvláštna, dokonca rozmarná choroba: pri infikovaní rovnakými mikroorganizmami u dvoch žien môže ten istý liek v prvom prípade dokonale zvládnuť svoju úlohu a v druhom prípade úplne zbytočný. Na prekonanie tohto ochorenia musíte jasne vedieť, ktoré testy sú potrebné, ktoré lieky sú najúčinnejšie. Vo videu nižšie hovorí skúsený technik ako sa vysporiadať s drozdom minimálne finančné prostriedky a úsilie.
Recenzie liečby
Tatyana, 24 rokov Prvýkrát som počul na prenatálnej klinike slová „candida colpitis“, keď som prišiel so sťažnosťami na svrbenie, biely výboj. Moja dovolenka v exotickom letovisku viedla k takému neočakávanému výsledku. Lekár predpísal liečebný kúsok: harmanček, Terzhinan, multivitamíny. Po niekoľkých týždňoch zmizli všetky príznaky drozdu.
Victoria, 51 Veľmi ma prekvapilo, keď po plánovanej konzultácii gynekológ objavil atrofickú kolpitídu - nič ma neobťažovalo. Ako sa ukázalo, choroba sa práve začala rozvíjať. Zachránil ma „ekofemín“ - prejdú mi závažné prejavy choroby. Teraz starostlivo sledujem svoje hormonálne pozadie, podporujem imunitu.
Julia, 27 rokov Ochorenie vzniklo počas tehotenstva. Lekár hneď niekoľko liekov zrušil - nemôžu sa užiť neskôr. Priebeh liečby Pimafucínom, príjem vitamínov, zachránil situáciu: dieťa sa narodilo silné, zdravé, neexistovali žiadne popôrodné komplikácie a cítil som sa skvele!